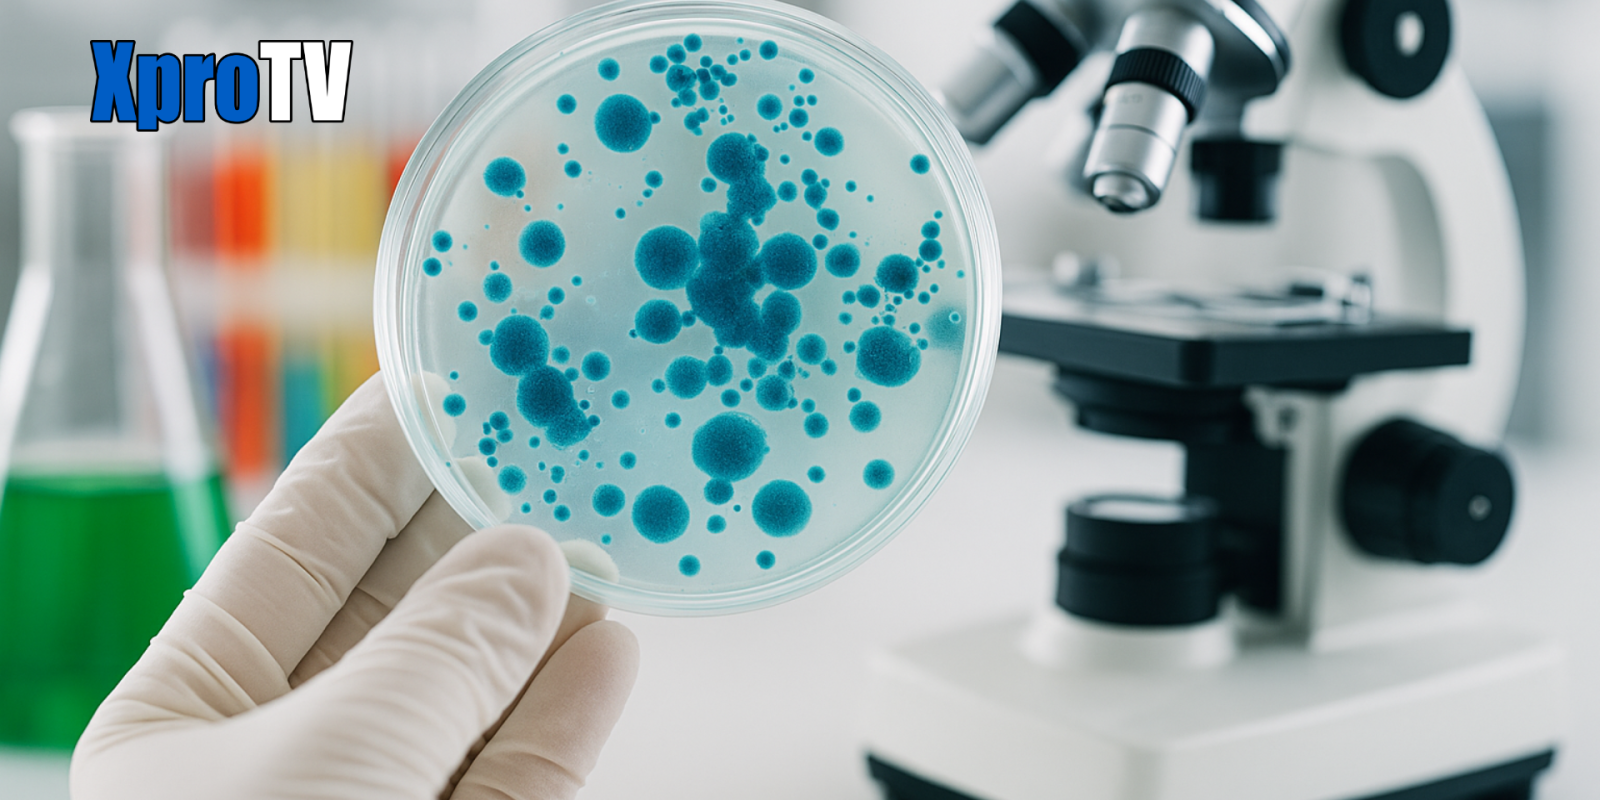

Cada 16 de junio se celebra el Día Internacional de la Biotecnología, una efeméride que busca resaltar el valor de esta disciplina científica en la sostenibilidad del planeta, la salud, la industria y el medio ambiente.
¿Por qué se celebra el 16 de junio?
La elección de esta fecha se debe al descubrimiento realizado en 1980 por Ananda Mohan Chakrabarty, quien desarrolló una bacteria del género Pseudomonas capaz de descomponer petróleo crudo, lo que marcó un hito en el tratamiento de derrames petroleros. Este avance fue reconocido legalmente por la Suprema Corte de los Estados Unidos al considerarlo objeto patentable, lo que dio origen a la industria biotecnológica moderna.
¿Qué es la Biotecnología?
La biotecnología es un conjunto de disciplinas que utilizan organismos vivos o partes de ellos (genes, enzimas, células) para crear o modificar productos y procesos con aplicaciones en salud, alimentación, industria, medio ambiente y más.
Tipos de Biotecnología (por colores)
La biotecnología se clasifica en ramas según sus aplicaciones principales:
- Biotecnología verde: Mejora cultivos para hacerlos más resistentes a plagas y fenómenos climáticos.
- Biotecnología roja: Desarrolla vacunas, medicamentos y terapias génicas.
- Biotecnología azul: Aprovecha los recursos marinos para crear productos cosméticos, farmacéuticos y de acuicultura.
- Biotecnología blanca: Se aplica en procesos industriales como la producción de biocombustibles y materiales sostenibles.
- Biotecnología gris: Enfocada en la restauración y protección del medio ambiente.
- Biotecnología amarilla: Relacionada con la nutrición y la mejora de alimentos.
- Biotecnología dorada: Es la bioinformática, encargada del análisis y gestión de datos genéticos (ADN, ARN, proteínas).
Aplicaciones actuales de la Biotecnología
La biotecnología ha sido clave en numerosos avances científicos y médicos, como:
- El desciframiento del genoma del virus SARS-CoV-2, durante la pandemia por COVID-19.
- El desarrollo de terapias génicas, la vacuna contra la Hepatitis B, la insulina y la hormona del crecimiento.
- La producción de alimentos transgénicos más nutritivos y resistentes.
- El diseño de materiales inteligentes y biodegradables en la industria.
- La recuperación de ambientes contaminados mediante el uso de plantas, microorganismos y enzimas.
La biotecnología es una herramienta clave para enfrentar los desafíos del presente y construir un futuro más saludable, justo y sostenible.